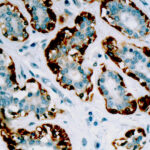

|
|---|
 Anti-CA-IX Anti-CA-IXBuy here |
 Anti-Calcitonin Anti-CalcitoninBuy here |
 Anti-Caldesmon Anti-CaldesmonBuy here |
 Anti-Caldesmon HMW, Smooth muscle Anti-Caldesmon HMW, Smooth muscleBuy here |
 Anti-Calponin Anti-CalponinBuy here |
 Anti-Calponin-1 Anti-Calponin-1Buy here |
 Anti-Calretinin Anti-CalretininBuy here |
 Anti-Calretinin Anti-CalretininBuy here |
 Anti-Calretinin Anti-CalretininBuy here |
 Anti-Calretinin Anti-CalretininBuy here |